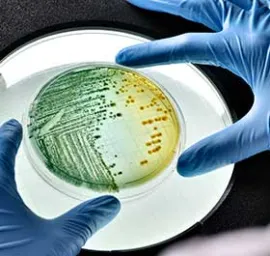
GLS Antimicrobial

GLS™ Thermoplastic Elastomers
We’ve developed the GLS™ line of thermoplastic elastomers from a wide range of technologies to suit an even wider variety of purposes. Our distinct product families cover performance features desired in markets as different as consumer packaged goods and industrial equipment – and everything in between.
If your application requires something even more special, our experts will work with you to develop unique formulations to help you create products that will dazzle your customers.
Featured

TPE Knowledge Center
Browse guides, trend reviews, technical bulletins and more – and don’t hesitate to contact us for more information.
More
GLS™ OnFlex™ Thermoplastic Elastomers
OnFlex TPEs add the performance and safety needed for applications such as automotive components.
More
GLS™ Versaflex™ Thermoplastic Elastomers
Give your products the grip and soft touch that your customers value -- TPEs make it possible.
MoreTechnologies
- Dynaflex™ Thermoplastic Elastomers
- Dynalloy™ Thermoplastic Elastomers
- GLS™ TPEs with Antimicrobial Technologies
- OnFlex™ Thermoplastic Elastomers
- Stat-Tech™ TPE Static Dissipative & Electrically Conductive Thermoplastic Elastomers
- Versaflex™ HC Thermoplastic Elastomers
- Versaflex™ Low Adhesive Build-up TPE for Protective Film Tack Layer
- Versaflex™ Non-Blooming TPEs for Consumer Electronics
- Versaflex™ PF Tack Layer For Surface Protective Films
- Versaflex™ TF Adhesive TPEs for Textile Fabrics
- Versaflex™ Thermoplastic Elastomers
- Versalloy™ Thermoplastic Elastomers
- Versollan™ Thermoplastic Elastomers
- reSound™ BIO Thermoplastic Elastomers
- reSound™ REC Recycled Content Thermoplastic Elastomers
- reSound™ Ultra-Low Carbon Footprint TPEs
Resources
TPE Knowledge Center
Learn the finer points of using TPEs to improve and enhance your products.

Marketing + Technical Info
Browse and download our literature to learn more about Avient solutions and services.